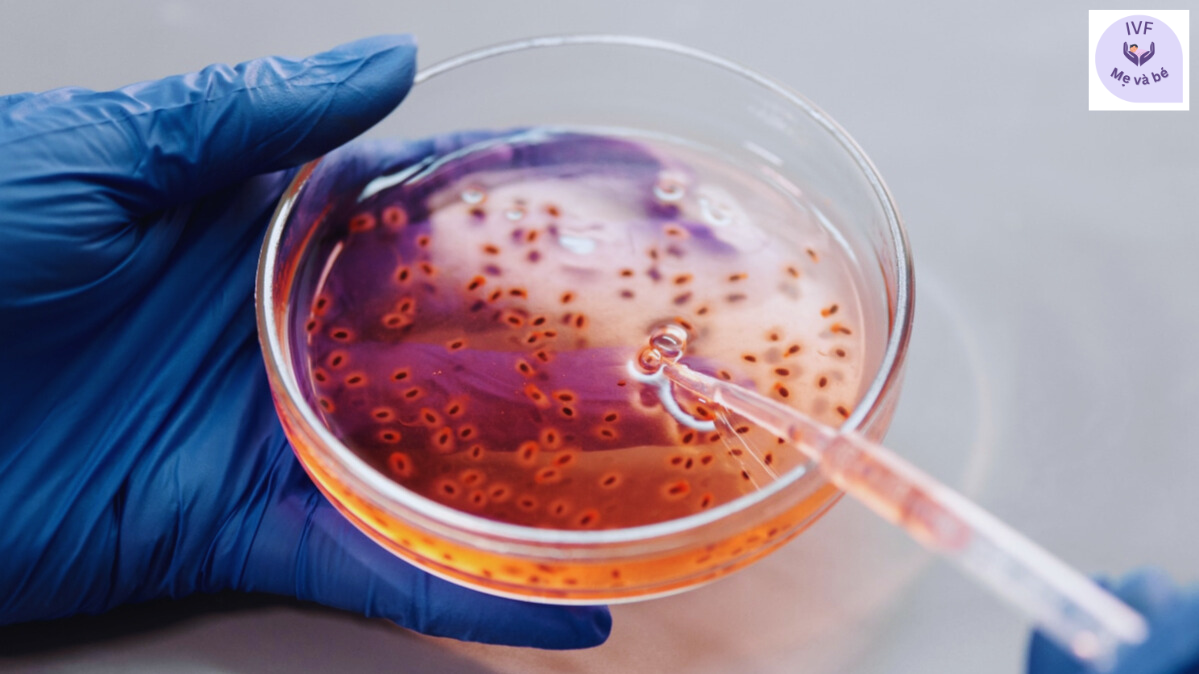
Kiểm tra chỉ số phân mảnh DNA tinh trùng (DFI)

IVF

Xét Nghiệm AMH Thấp Bao Nhiêu Thì Cần Làm IVF Ngay?
Trong hành trình chuẩn bị làm mẹ, AMH (Anti-Müllerian Hormone) chính là chỉ số quan trọng nhất để đánh giá chính xác dự trữ buồng trứng của người phụ nữ. Chỉ số này phản ánh số lượng trứng còn lại trên buồng trứng và là thước đo để các bác sĩ tiên lượng khả năng sinh sản. Vậy khi nào chỉ số này rơi vào "vòng báo động" và mức AMH thấp bao nhiêu thì các cặp vợ chồng nên cân nhắc can thiệp thụ tinh trong ống nghiệm (IVF) ngay để không bỏ lỡ cơ hội vàng?
Đọc thêm >
Công Nghệ PGT-A Tại Thái Lan Giúp Sàng Lọc Những Gì?
Trong kỷ nguyên của y học chính xác, PGT-A (Preimplantation Genetic Testing for Aneuploidies) – Kỹ thuật xét nghiệm di truyền tiền chuyển phôi nhằm sàng lọc lệch bội nhiễm sắc thể – đã trở thành một phần không thể thiếu trong các phác đồ IVF cao cấp tại Thái Lan.. Vậy cụ thể, công nghệ PGT-A tại Thái Lan giúp sàng lọc những gì và mang lại lợi ích vượt trội ra sao cho các cặp vợ chồng? Bài viết dưới đây sẽ giải đáp chi tiết góc độ chuyên môn này.
Đọc thêm >
Lợi Ích Của Việc Bổ Sung Hormone Tăng Trưởng (GH) Trong Phác Đồ IVF Cao Cấp Tại Thái Lan
Trong hành trình tối ưu hóa tỷ lệ thành công của các ca thụ tinh trong ống nghiệm (IVF), y học hiện đại không ngừng nghiên cứu và ứng dụng các liệu pháp hỗ trợ chuyên sâu. Tại trung tâm hỗ trợ sinh sản hàng đầu Thái Lan, việc cá nhân hóa phác đồ điều trị thông qua việc bổ sung Hormone tăng trưởng (Growth Hormone - GH) đang được xem là một "chìa khóa vàng" giúp nhiều gia đình hiện thực hóa ước mơ làm cha mẹ, đặc biệt là những trường hợp có ca bệnh khó.
Đọc thêm >
Hiện Tượng Trứng Rụng Nhưng Không Chín: Nguyên Nhân Thầm Lặng Gây Khó Muộn Và Giải Pháp Toàn Diện
Trong hành trình tìm kiếm con yêu, nhiều cặp vợ chồng đối mặt với tình trạng dù canh đúng ngày rụng trứng, sức khỏe tổng thể bình thường nhưng quả ngọt vẫn chưa đến. Một trong những nguyên nhân chuyên sâu được phát hiện qua các xét nghiệm cận lâm sàng chính là hiện tượng trứng rụng nhưng không chín (Immature Ovulation).
Đọc thêm >
Kiểm tra sức khỏe trước IVF/ICSI
Kiểm tra sức khỏe định kỳ là điều mà nhiều người làm hàng năm. Tuy nhiên, kiểm tra định kỳ khác với các xét nghiệm cụ thể cần thiết để chuẩn bị cho IVF/ICSI. Hãy cùng khám phá sự khác biệt và những xét nghiệm nào cần thiết
Đọc thêm >
Tầm Soát Di Truyền Trước Khi Mang Thai: Bước Khởi Đầu Thông Minh Cho Một Thai Kỳ Khỏe Mạnh
Tầm soát di truyền trước khi mang thai giúp phát hiện sớm các nguy cơ di truyền tiềm ẩn ở cả bố và mẹ, từ đó giảm thiểu khả năng em bé sinh ra mắc các bệnh lý di truyền. Đây là bước chuẩn bị quan trọng giúp các cặp vợ chồng chủ động trong kế hoạch sinh con và lựa chọn phương pháp điều trị phù hợp nếu cần thiết.
Đọc thêm >
Chỉ Số hCG Sau Chuyển Phôi IVF: 12 Điều Bạn Cần Biết
Bạn đang băn khoăn về chỉ số hCG sau chuyển phôi? Tự hỏi điều gì sẽ diễn ra trong những ngày tiếp theo của hành trình IVF? Việc hiểu rõ về hormone hCG - loại hormone quan trọng trong giai đoạn đầu thai kỳ - sẽ giúp bạn an tâm hơn trong quá trình theo dõi kết quả.
Đọc thêm >
Các xét nghiệm vô sinh nam: Bao gồm những gì?
Hiện nay, vô sinh nam là một vấn đề phổ biến trên toàn thế giới. Các nghiên cứu cho thấy, khoảng 15% các cặp đôi gặp khó khăn trong việc có con, trong đó 30–40% trường hợp nguyên nhân đến từ nam giới. Thực tế này cho thấy tầm quan trọng của việc chẩn đoán chính xác nguyên nhân gây vô sinh nam.
Đọc thêm >
Các Phương Pháp Điều Trị Oligospermia (Tinh Trùng Ít)
Tinh trùng ít (Oligospermia) là một trong những nguyên nhân phổ biến dẫn đến tình trạng khó có con ở nam giới. Đây là tình trạng tinh dịch có số lượng tinh trùng thấp hơn mức bình thường, làm giảm khả năng thụ thai tự nhiên.
Đọc thêm >
Tinh Trùng Yếu (Asthenospermia) – Nguyên Nhân, Dấu Hiệu Và Giải Pháp Điều Trị
Có nhiều nguyên nhân ảnh hưởng đến quá trình sản xuất, chất lượng hoặc khả năng di chuyển của tinh trùng — trong đó có Asthenospermia, hay còn gọi là tinh trùng yếu. Đây là tình trạng tinh trùng có khả năng di chuyển thấp, khó di chuyển hiệu quả để gặp trứng và thụ tinh.
Đọc thêm >
Top 10 Thực Phẩm Giúp Tinh Trùng Khỏe Mạnh, Tăng Cơ Hội Có Con
Một trong những yếu tố quan trọng nhất ảnh hưởng đến khả năng sinh sản của nam giới chính là số lượng tinh trùng. Bài viết dưới đây sẽ giúp bạn hiểu rõ hơn về tầm quan trọng của số lượng tinh trùng và gợi ý Top 10 loại thực phẩm tự nhiên giúp cải thiện số lượng và chất lượng tinh trùng hiệu quả.
Đọc thêm >
AMH, Anti-TPO, Anti-TG là gì?
Nếu bạn có chỉ số AMH thấp hoặc đang gặp vấn đề tuyến giáp như Anti-TPO/Anti-TG cao, việc điều trị kịp thời và có kế hoạch sinh con phù hợp là điều vô cùng quan trọng – đặc biệt nếu đang cân nhắc hoặc thực hiện IVF.
Đọc thêm >
Cà phê, rượu, thuốc lá có thể ảnh hưởng đến khả năng sinh sản
Việc tiêu thụ rượu, cà phê và thuốc lá có thể ảnh hưởng đáng kể đến khả năng sinh sản ở cả nam và nữ. Những thói quen này làm suy giảm chất lượng trứng và tinh trùng, ảnh hưởng đến quá trình rụng trứng, thụ thai và cả khả năng giữ thai sau khi thụ tinh.
Đọc thêm >
Tỷ lệ thành công IVF ở phụ nữ trên 40 tuổi
IVF (thụ tinh trong ống nghiệm) đã trở thành tia hy vọng cho nhiều người đang đối mặt với tình trạng hiếm muộn. Đặc biệt, phụ nữ trên 40 tuổi thường tìm đến IVF như một giải pháp khả thi khi khả năng sinh sản tự nhiên bắt đầu suy giảm rõ rệt. Dù vậy, tỷ lệ thành công IVF ở độ tuổi này lại phụ thuộc vào nhiều yếu tố và có sự khác biệt đáng kể giữa từng trường hợp. Hiểu rõ những yếu tố ảnh hưởng sẽ giúp người bệnh có sự chuẩn bị tốt hơn.
Đọc thêm >
Xét nghiệm beta hCG sau 14 ngày chuyển phôi
Khoảng thời gian 14 ngày sau chuyển phôi luôn đầy hy vọng và hồi hộp đối với các cặp vợ chồng đang thực hiện thụ tinh trong ống nghiệm (IVF). Xét nghiệm beta hCG sau 14 ngày chuyển phôi là cột mốc quan trọng, giúp đánh giá ban đầu về khả năng thành công của quá trình điều trị.
Đọc thêm >
Tác Dụng Phụ Của Tiêm IVF
Bắt đầu hành trình phức tạp của Thụ Tinh Trong Ống Nghiệm (IVF), là một bước quan trọng hướng tới giấc mơ làm cha mẹ. Một yếu tố quan trọng thường chiếm vị trí trung tâm đó là việc tiêm thuốc IVF. Trong bài viết này, chúng ta sẽ cùng khám phá thông tin về các mũi tiêm này, giải mã quy trình và thảo luận về các tác dụng phụ tiềm ẩn của tiêm IVF.
Đọc thêm >
Thai kỳ IVF khác với thai kỳ tự nhiên như thế nào?
Mang thai là một hành trình kỳ diệu, bất kể nó bắt đầu như thế nào. Tuy nhiên, có những sự khác biệt rõ rệt giữa thai kỳ được thụ tinh trong ống nghiệm (IVF) và thai kỳ tự nhiên. Hãy cùng khám phá sự khác biệt giữa thai kỳ IVF và thai kỳ tự nhiên, những sự khác biệt này theo cách đơn giản nhưng đầy đủ thông tin, giúp bạn hiểu những gì có thể xảy ra trong mỗi tình huống.
Đọc thêm >
Mức độ HCG sau khi chuyển phôi trong IVF: 12 điều quan trọng cần biết
Bạn có thắc mắc về mức độ hCG sau khi chuyển phôi không? Bạn đang tự hỏi sẽ có những gì xảy ra trong những ngày sau bước quan trọng này trong hành trình IVF của mình? Trong bài viết này, chúng tôi sẽ khám phá 12 điều về hCG, một hormone được sản xuất trong giai đoạn đầu của thai kỳ, quan trọng để duy trì thai kỳ và chỉ ra sự tiến triển của nó. Việc theo dõi mức độ hCG sau khi chuyển phôi trong IVF trở nên quan trọng để xác nhận và hỗ trợ một thai kỳ khỏe mạnh.
Đọc thêm >
Số lượng mũi tiêm cần thiết cho điều trị IVF là bao nhiêu?
Giống như các phương pháp điều trị khác, IVF cũng yêu cầu sử dụng thuốc và các mũi tiêm IVF để hỗ trợ mang thai. Các chuyên gia sẽ sử dụng mũi tiêm và thuốc để hỗ trợ quá trình thụ tinh, cấy phôi và phát triển phôi.
Đọc thêm >
Những mũi tiêm IVF thường được sử dụng
Tại trung tâm của hành trình IVF có một yếu tố quan trọng: việc sử dụng các mũi tiêm đóng vai trò then chốt trong từng bước của quy trình IVF. Trong bài viết chi tiết này, chúng ta sẽ tìm hiểu về các loại mũi tiêm IVF khác nhau, chức năng của chúng, và cách chúng góp phần vào sự thành công của điều trị hiếm muộn tại các phòng khám vô sinh hàng đầu.
Đọc thêm >
Tình trạng thất bại trong việc cấy phôi
Tình trạng thất bại trong việc cấy phôi có nghĩa là phôi được tạo ra từ quá trình thụ tinh không thể cấy vào niêm mạc tử cung một cách hoàn chỉnh, đây là bước quan trọng trong việc bắt đầu quá trình mang thai. Khi xảy ra tình trạng này, việc mang thai sẽ không diễn ra.
Đọc thêm >
Câu Hỏi Cần Hỏi Bác Sĩ Sau Chu Kỳ IVF Thất Bại
Bắt đầu hành trình thụ tinh ống nghiệm (IVF) là một quá trình vừa đầy hy vọng nhưng cũng không kém phần thử thách. Tuy nhiên, mặc dù đã có kế hoạch kỹ lưỡng và nỗ lực không ngừng, các chu kỳ IVF không phải lúc nào cũng mang lại kết quả như mong đợi. Trong những khoảnh khắc thất vọng như vậy, việc giao tiếp hiệu quả với bác sĩ là vô cùng quan trọng. Có một số câu hỏi cần hỏi bác sĩ sau khi chu kỳ IVF thất bại, điều này có thể mang lại sự rõ ràng, cái nhìn sâu sắc và có lẽ quan trọng nhất là con đường phía trước.
Đọc thêm >
Tỷ Lệ Thành Công Của IVF Theo Độ Tuổi
Thụ tinh trong ống nghiệm (IVF) là một phương pháp rất phổ biến giúp giải quyết tình trạng vô sinh. Tuổi tác là yếu tố quan trọng trong việc thành công của IVF. Khi phụ nữ lớn tuổi, chất lượng và số lượng trứng có thể giảm sút, điều này ảnh hưởng lớn đến kết quả IVF và tỷ lệ thành công của IVF theo độ tuổi.
Đọc thêm >
Cơ thể thay đổi sau khi chuyển phôi như thế nào?
Trong blog này, chúng ta sẽ xem xét kỹ hơn những thay đổi về cảm xúc và thể chất của cơ thể sau khi chuyển phôi có thể diễn ra sau khi chuyển phôi, cung cấp những hiểu biết có giá trị về những gì mong đợi liên quan đến phản ứng của cơ thể bạn.
Đọc thêm >
Tại Sao IVF Lại Thất Bại Mặc Dù Có Phôi Tốt : Tìm Hiểu Cùng Các Chuyên Gia
Thụ tinh ống nghiệm (IVF) là một phương pháp hỗ trợ sinh sản nhân tạo, trong đó trứng và tinh trùng được thụ tinh trong phòng thí nghiệm, và các phôi khỏe mạnh sẽ được cấy vào tử cung của người mẹ. Tuy nhiên, mặc dù các phôi có chất lượng tốt, nhiều cặp đôi và cá nhân vẫn phải đối mặt với sự thất vọng vì quy trình IVF không thành công. Đây là một trải nghiệm rất căng thẳng và khó khăn đối với những người coi IVF là cơ hội cuối cùng để thực hiện ước mơ làm cha mẹ của mình.
Đọc thêm >
Biểu đồ chế độ ăn uống sau khi chuyển phôi: Hướng dẫn toàn diện
Chuyển phôi đánh dấu một giai đoạn quan trọng trong hành trình IVF. Sau khi dự đoán và các bước tỉ mỉ dẫn đến thời điểm này, việc tạo ra một môi trường lành mạnh để cấy ghép trở nên tối quan trọng. Trong khi can thiệp y tế đóng vai trò không thể thiếu trong việc tối ưu hóa sự thành công của quá trình cấy ghép sau khi chuyển phôi, thì lựa chọn chế độ ăn uống cũng đóng vai trò quan trọng trong việc ảnh hưởng đến sự thành công của quá trình này.
Đọc thêm >
Cách tăng khả năng sinh sản ở độ tuổi 30
Khi phụ nữ bước vào độ tuổi 30, nhiều người bắt đầu nghĩ về khả năng sinh con của mình và khả năng lập gia đình. Đây là thời điểm sự nghiệp thường được thiết lập, các mối quan hệ được củng cố và mong muốn có con trở nên rõ ràng hơn. Trong blog này, chúng ta sẽ khám phá những mẹo thực tế dành cho phụ nữ ở độ tuổi 30 về cách tăng khả năng sinh sản ở độ tuổi 30 một cách tự nhiên và tăng cơ hội thụ thai.
Đọc thêm >
Mất cân bằng nội tiết tố sau khi IVF thất bại
Một trong những hậu quả tiềm ẩn của IVF không thành công là mất cân bằng nội tiết tố, một tình trạng có thể ảnh hưởng sâu sắc đến cả sức khỏe thể chất và tinh thần. Trong blog này, chúng tôi sẽ khám phá sự mất cân bằng hormone sau khi IVF thất bại, thảo luận về lý do tại sao nó xảy ra, các triệu chứng của nó và cách quản lý nó.
Đọc thêm >
10 lý do hàng đầu khiến IVF thất bại
Bài viết dưới đây khám phá những lý do chủ yếu khiến IVF có thể thất bại. Ngoài ra, chúng ta sẽ thảo luận về những gì xảy ra với cơ thể bạn sau một chu kỳ thất bại, các giai đoạn cảm xúc của sự đau buồn sau đó và các bước bạn có thể thực hiện sau nhiều chu kỳ thất bại.
Đọc thêm >
Dấu hiệu tích cực sau khi chuyển phôi
Hiểu được các dấu hiệu tích cực sau chuyển phôi sẽ giúp bạn vượt qua giai đoạn quan trọng này với sự tự tin và nhận thức tốt hơn. Trong bài viết này, chúng ta sẽ điểm qua những thay đổi và triệu chứng phổ biến hàng ngày mà bạn có thể gặp phải sau khi chuyển phôi, giúp bạn hiểu điều gì là bình thường và điều gì có thể cần sự chăm sóc thêm.
Đọc thêm >
Dấu hiệu tiêu cực sau khi chuyển phôi
Quá trình chuyển phôi trong công nghệ hỗ trợ sinh sản (ART) là một cột mốc quan trọng và đầy phấn khởi. Những ngày sau đó thường được mong đợi với nhiều hy vọng, nhưng đồng thời cũng cần chú ý theo dõi các triệu chứng có thể chỉ ra những mối lo ngại hoặc khó khăn. Mặc dù nhiều phụ nữ cảm thấy tích cực, nhưng điều quan trọng là phải nhận biết được các triệu chứng xuất hiện từng ngày sau khi chuyển phôi và biết cách nhận ra những dấu hiệu tiêu cực có thể gây lo ngại.
Đọc thêm >
Kiểm tra chỉ số phân mảnh DNA tinh trùng (DFI)
Theo nhiều nghiên cứu, có 15 – 25% trường hợp bị vô sinh nam liên quan tới phân mảnh DNA tinh trùng. Vì vậy, trong chẩn đoán vô sinh nam, cần thực hiện xét nghiệm phân mảnh DNA tinh trùng để đưa ra phương án điều trị hiếm muộn hiệu quả hơn.
Đọc thêm >
PICSI tối ưu hoá lựa chọn tinh trùng cho thụ tinh ống nghiệm
Việc chọn lọc tinh trùng sinh lý thông qua lựa chọn tinh trùng có khả năng bám với hyaluronic acid (hyaluronan – HA) trong đĩa chuyên dụng PICSI dường như là phương pháp thích hợp để thực hiện thụ tinh ống nghiệm với tinh trùng tốt hơn.
Đọc thêm >
Hướng dẫn cách giúp các cặp vợ chồng có con dễ dàng hơn
Muốn có con nhưng không có thai hoặc khó có con có thể là vấn đề mà nhiều cặp vợ chồng đang gặp phải, khiến họ băn khoăn không biết nguyên nhân là gì và liệu mình có thể có con hay không. Blog này sẽ giải đáp câu hỏi tại sao chúng ta khó mang thai hơn người bình thường; gợi ý để lập kế hoạch mang thai dễ dàng hơn?
Đọc thêm >
Chuyển phôi tươi hay phôi đông lạnh tốt hơn?
Sau khi nuôi phôi đến giai đoạn 5 ngày hoặc phôi nang thì bước tiếp theo sẽ là chuyển phôi vào tử cung của bà mẹ; Sự khác biệt giữa chuyển phôi tươi và đông lạnh là gì? Loại nào tốt hơn?
Đọc thêm >
Vô sinh ở nữ: Nguyên nhân, triệu chứng, điều trị và xét nghiệm
Việc giải quyết tình trạng vô sinh ở nữ giới có tầm quan trọng cao do tác động sâu sắc của nó đối với cá nhân và các cặp đôi, ảnh hưởng đến sức khỏe cảm xúc và mục tiêu kế hoạch hóa gia đình của họ. Bài viết này cung cấp thông tin khám phá toàn diện về tình trạng vô sinh ở nữ giới, đi sâu vào nguyên nhân, triệu chứng, phương án điều trị và xét nghiệm chẩn đoán.
Đọc thêm >
Mang thai IVF khác với mang thai tự nhiên như thế nào
Mang thai là một hành trình kỳ diệu, bất kể nó bắt đầu như thế nào. Tuy nhiên, có sự khác biệt rõ ràng giữa việc mang thai được hình thành thông qua thụ tinh trong ống nghiệm (IVF) và những trường hợp xảy ra tự nhiên. Hãy cùng tìm hiểu IVF mang thai khác với mang thai tự nhiên như thế nào trong bài viết dưới đây.
Đọc thêm >
Điều trị bằng phương pháp IVF/ICSI có sinh đôi được không?
Phương pháp IVF/ICSI có thể sinh đôi, nhưng không đảm bảo 100% rằng cả hai phôi thai sẽ được cấy đồng thời
Đọc thêm >
Điều trị ICSI
ICSI hay Tiêm tinh trùng vào bào tương noãn là một phương pháp điều trị y tế hiệu quả cho chứng vô sinh ở nam giới. Thủ tục y tế này đang giúp hàng ngàn cặp vợ chồng vô sinh có được một đứa con. Đây được coi là một kỹ thuật sinh sản thay thế và là sự mở rộng y tế của điều trị IVF.
Đọc thêm >
IVF, công nghệ thay thế cho các cặp vợ chồng vô sinh
Nhiều yếu tố dẫn đến vô sinh, bao gồm rụng trứng bất thường, tử cung bất thường, ít di chuyển chậm, rối loạn chức năng. IVF là một công nghệ thay thế thông qua thụ tinh ngoài cơ thể và chuyển phôi thai trở lại tử cung để mang thai.
Đọc thêm >
Những lưu ý khi chuẩn bị cho việc điều trị IVF
IVF là phương pháp hỗ trợ sinh sản hiện đại và hiệu quả hiện nay, áp dụng cho ca khó hoặc đã thất bại với cách chữa trị khác. Để hành trình tìm kiếm con yêu trở nên thuận lợi, các ông bố bà mẹ tương lai không nên bỏ qua 7 lưu ý chuẩn bị về sức khỏe, thời gian và tài chính.
Đọc thêm >
Hướng dẫn về dinh dưỡng sinh sản tối ưu
Dinh dưỡng ảnh hưởng đáng kể đến tỷ lệ thành công IVF. Thói quen ăn uống hợp lý, bao gồm ăn một chế độ ăn uống cân bằng và chọn thực phẩm phù hợp, rất quan trọng để đảm bảo kết quả IVF khả thi với các biến chứng tối thiểu.
Đọc thêm >
Hỏi đáp về IVF
Thụ tinh trong ống nghiệm hay IVF đã viết nên giấc mơ hạnh phúc cho nhiều cặp vợ chồng hiếm muộn. Đây là phương pháp hiện đại và có nhiều ưu việt nhưng nhiều người vẫn chưa hiểu rõ dẫn đến việc bỏ lỡ thời điểm vàng để thực hiện. Dưới đây là những câu hỏi thường gặp khi làm IVF và giải đáp từ chuyên gia.
Đọc thêm >
Theo dõi chu kỳ IVF của bạn
Kế hoạch hóa gia đình bằng IVF có thể là một hành trình khó khăn. Sau đây là hướng dẫn cung cấp mốc thời gian và tài liệu tham khảo.
Đọc thêm >
Các câu hỏi liên quan đến điều trị vô sinh bằng phương pháp IVF và ICSI
Nhiều bạn thắc mắc về IVF và ICI có gì khác nhau? Loại nào tốt hơn? Chúng tôi đã tổng hợp những câu hỏi mà nhiều người thắc mắc để giúp bạn đưa ra quyết định tại đây.
Đọc thêm >
Điều trị vô sinh bằng phương pháp ICSI
Phương pháp điều trị ICSI đang ngày càng phổ biến do tỷ lệ thành công cao, điều này mang lại hy vọng cho hàng ngàn cặp vợ chồng thực hiện giấc mơ tìm kiếm những đứa trẻ của mình.
Đọc thêm >
Thực phẩm cần tránh khi thực hiện IVF
Một chế độ ăn lành mạnh rất tốt cho quá trình thực hiện IVF vì tinh trùng và trứng khỏe mạnh là điều cần thiết cho một thai kỳ khỏe mạnh.
Đọc thêm >
Số lượng trứng bao nhiêu là tốt khi thụ tinh ống nghiệm IVF?
Số lượng trứng tối thiểu sẽ là 2 và nếu phụ nữ càng có nhiều trứng đạt chất lượng thì cơ hội tạo phôi và mang thai càng cao.
Đọc thêm >
Trung tâm Hỗ trợ Sinh sản & Phòng khám IVF
Mỗi năm, hàng triệu cặp vợ chồng trên thế giới phải đối mặt với tình trạng vô sinh. Tổ chức Y tế Thế giới ước tính rằng khoảng 1 trong 6 những người trong độ tuổi sinh sản gặp phải vấn đề này. Vô sinh có thể do nam, nữ hoặc cả hai.
Đọc thêm >
Quá trình thụ tinh trong ống nghiệm diễn ra như thế nào?
Thụ tinh trong ống nghiệm (IVF) là kỹ thuật được áp dụng trong điều trị vô sinh, mang lại tỷ lệ thành công cao. Một chu kỳ thụ tinh ống nghiệm gồm bước chuẩn bị, kích trứng, theo dõi nang noãn, chọc hút trứng, thụ tinh, chuyển phôi, bổ sung nội tiết tố, thử thai và theo dõi.
Đọc thêm >
5 giai đoạn của IVF
Chúng ta hãy cùng tìm hiểu về quy trình này và ý nghĩa của nó đối với những nỗ lực trong tương lai của bạn để có con.
Đọc thêm >
Tại sao IVF thất bại với phôi thai tốt: Tìm hiểu cùng chuyên gia
Tại sao IVF lại thất bại với phôi tốt? Trong blog này, chúng ta sẽ đi sâu vào lý do tại sao quy trình IVF có thể thất bại ngay cả với phôi tốt và cách xử lý tình trạng IVF thất bại.
Đọc thêm >
Chuẩn bị những gì trước khi tư vấn IVF
Chúng tôi sẽ cung cấp cho bạn những lời khuyên thiết thực và hiểu biết sâu sắc về cách chuẩn bị cho tư vấn IVF. Chúng ta hãy cùng nhau bắt đầu cuộc hành trình này, đặt nền móng cho một cuộc tư vấn hiệu quả và cuối cùng là một phương pháp điều trị IVF thành công.
Đọc thêm >
Những điều bạn nên biết trước khi thực hiện IVF
Bắt đầu hành trình IVF của bạn có thể là một hành trình vừa khó khăn vừa đầy hy vọng. Việc trang bị cho mình những kiến thức, hiểu biết và sự hỗ trợ để hoàn thành hành trình IVF thành công rất quan trọng với tất cả những người chuẩn bị, đang và sẽ thực hiện lựa chọn này.
Đọc thêm >
Làm thế nào để IVF thành công ngay lần đầu tiên?
Các bậc cha mẹ thường xuyên suy ngẫm về tỷ lệ thành công của IVF. IVF thành công đến mức nào và bạn có thể làm gì để cải thiện khả năng thành công? Khả năng mang thai bằng IVF sẽ phụ thuộc vào một số yếu tố, bao gồm tuổi tác, sức khỏe, trọng lượng cơ thể, loại vô sinh, loại IVF được sử dụng, chất lượng phôi và khả năng của trung tâm sinh sản.
Đọc thêm >
Mang thai IVF khác với mang thai tự nhiên như thế nào?
Có sự khác biệt rõ rệt giữa các trường hợp mang thai được thụ thai thông qua thụ tinh trong ống nghiệm (IVF) và những trường hợp xảy ra tự nhiên. Hãy cùng khám phá những khác biệt này một cách đơn giản nhưng đầy đủ thông tin, nhằm giúp bạn hiểu những gì sẽ xảy ra trong từng tình huống.
Đọc thêm >